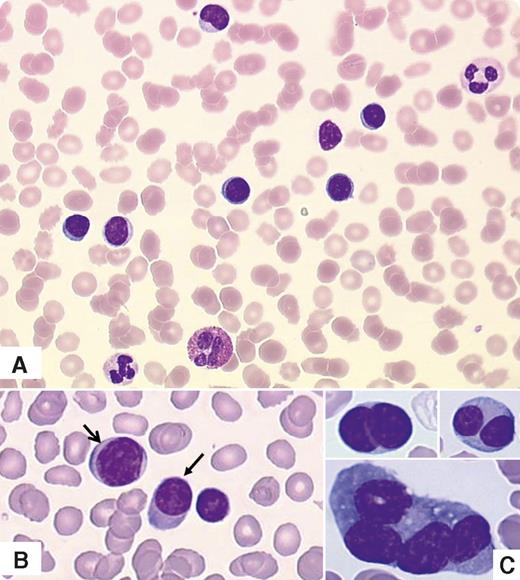
A 79-year-old woman was admitted for severe renal failure, hyperkalemia, hypercalcemia, fatigue, and nausea. She had a 7-year history of monoclonal gammopathy of undetermined significance with immunoparesis and osteoporosis. Complete blood count revealed leukocytosis (33 × 109/L) characterized as lymphocytosis by the analyzer (80%), thrombopenia (90 × 109/L), and anemia (11 g/dL) without neutropenia. Careful examination of blood smears revealed mature small cells, with round nuclei and a high nuclear-cytoplasmic ratio associated with erythrocyte rouleaux (panel A). She had a serum immunoglobulin G-κ level of 6.2 g/L. Flow cytometry diagnosed plasma cell leukemia, showing 70% of nucleated cells expressing bright CD138 and CD38, CD20 without CD19, CD56/CD28 or CD45, and monotypic cytoplasmic κ light chains. This prompted a more thorough examination of the peripheral cells. Some of the small cells had plasma cell features with a perinuclear hof and sometimes an eccentric nucleus (arrows in panel B). Pleomorphic plasma cells were observed on bone marrow smears (giant, multinucleated; panel C). Further exploration showed both a del17p and a p53 mutation. / The patient received 8 cycles of bortezomib (Velcade)/cyclophosphamide/dexamethasone and relapsed 18 months later, again with peripheral lymphoplasmacytic infiltration mistaken for lymphocytes by the analyzer. This case emphasizes the need to review the blood smear in patients with markedly abnormal values or a suspected hematologic disorder.

A 79-year-old woman was admitted for severe renal failure, hyperkalemia, hypercalcemia, fatigue, and nausea. She had a 7-year history of monoclonal gammopathy of undetermined significance with immunoparesis and osteoporosis. Complete blood count revealed leukocytosis (33 × 109/L) characterized as lymphocytosis by the analyzer (80%), thrombopenia (90 × 109/L), and anemia (11 g/dL) without neutropenia. Careful examination of blood smears revealed mature small cells, with round nuclei and a high nuclear-cytoplasmic ratio associated with erythrocyte rouleaux (panel A). She had a serum immunoglobulin G-κ level of 6.2 g/L. Flow cytometry diagnosed plasma cell leukemia, showing 70% of nucleated cells expressing bright CD138 and CD38, CD20 without CD19, CD56/CD28 or CD45, and monotypic cytoplasmic κ light chains. This prompted a more thorough examination of the peripheral cells. Some of the small cells had plasma cell features with a perinuclear hof and sometimes an eccentric nucleus (arrows in panel B). Pleomorphic plasma cells were observed on bone marrow smears (giant, multinucleated; panel C). Further exploration showed both a del17p and a p53 mutation.
The patient received 8 cycles of bortezomib (Velcade)/cyclophosphamide/dexamethasone and relapsed 18 months later, again with peripheral lymphoplasmacytic infiltration mistaken for lymphocytes by the analyzer. This case emphasizes the need to review the blood smear in patients with markedly abnormal values or a suspected hematologic disorder.
A 79-year-old woman was admitted for severe renal failure, hyperkalemia, hypercalcemia, fatigue, and nausea. She had a 7-year history of monoclonal gammopathy of undetermined significance with immunoparesis and osteoporosis. Complete blood count revealed leukocytosis (33 × 109/L) characterized as lymphocytosis by the analyzer (80%), thrombopenia (90 × 109/L), and anemia (11 g/dL) without neutropenia. Careful examination of blood smears revealed mature small cells, with round nuclei and a high nuclear-cytoplasmic ratio associated with erythrocyte rouleaux (panel A). She had a serum immunoglobulin G-κ level of 6.2 g/L. Flow cytometry diagnosed plasma cell leukemia, showing 70% of nucleated cells expressing bright CD138 and CD38, CD20 without CD19, CD56/CD28 or CD45, and monotypic cytoplasmic κ light chains. This prompted a more thorough examination of the peripheral cells. Some of the small cells had plasma cell features with a perinuclear hof and sometimes an eccentric nucleus (arrows in panel B). Pleomorphic plasma cells were observed on bone marrow smears (giant, multinucleated; panel C). Further exploration showed both a del17p and a p53 mutation.
The patient received 8 cycles of bortezomib (Velcade)/cyclophosphamide/dexamethasone and relapsed 18 months later, again with peripheral lymphoplasmacytic infiltration mistaken for lymphocytes by the analyzer. This case emphasizes the need to review the blood smear in patients with markedly abnormal values or a suspected hematologic disorder.
For additional images, visit the ASH IMAGE BANK, a reference and teaching tool that is continually updated with new atlas and case study images. For more information visit http://imagebank.hematology.org.
This feature is available to Subscribers Only
Sign In or Create an Account Close Modal